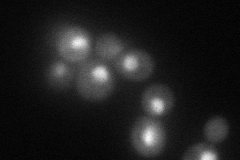
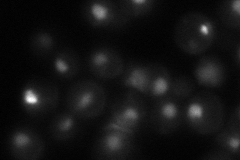
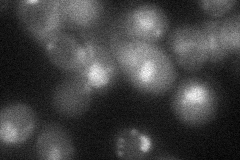
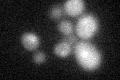
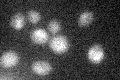

View description
Subunit (145 kDa) of TFIID and SAGA complexes, involved in RNA polymerase II transcription initiation and in chromatin modification
Localization:
Intensity:
Fold change:
Significance:
-
C’ GFP library in SD

below threshold15.3 -
N' NOP1pr-GFP in SD

nucleus100.3 -
N' TEF2pr-mCherry in SD
nucleus70.6061 -
N' NATIVEpr-GFP in SD
nucleus57.1515 -
N' TEF2pr-VC and Cyto-VN in SD
nucleus32.6467 -
C’ GFP library in SD+DTT
cytosol17.121.11No -
C’ GFP library in SD+H2O2

cytosol12.610.82No -
C’ GFP library in Starvation Media
cytosol19.661.28No -
C’ GFP library on the background of Pup2-DaMP

below threshold -
C’ GFP library on the background of CCT mutant

below threshold15.34661.00208No
